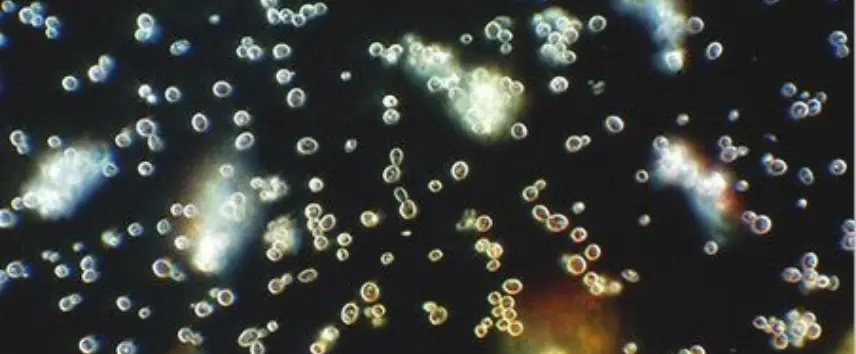
Tek Bir Damla, Binlerce Sır: Vücudunuzun Canlı Haritası Karanlık Alan Mikroskobu image

Hiç "bir şeylerin yolunda gitmediğini" hissettiğiniz, ancak tüm standart laboratuvar testlerinizin "normal" çıktığı oldu mu? Yorgunluk, beyin sisi, sindirim sorunları veya tanımlayamadığınız bir halsizlik... Modern tıp genellikle hastalıkları teşhis etmede harikadır, peki ya sağlığın kendisini, yani vücudumuzun iç ekosisteminin kalitesini nasıl ölçebiliriz?
Cellavia'da, sağlığa bakış açınızı kökten değiştirecek bir pencere sunuyoruz: Karanlık Alan Mikroskobu ile Canlı Kan Analizi. Bu, standart testlerin ötesine geçerek, kanınızın sadece "ne" içerdiğini değil, aynı zamanda "nasıl" davrandığını ve içinde bulunduğu "ortamın" kalitesini gözler önüne seren devrim niteliğinde bir yöntemdir.
Karanlık Alan Mikroskobu Nedir? Standart Testlerden Farkı Ne?
Standart kan testlerini, bir ülkenin nüfus sayımına benzetebiliriz: Kaç kişi var, sayıları normal mi? Bu değerli bir bilgidir.
Karanlık Alan Mikroskobu ise o ülkenin canlı bir uydu görüntüsü gibidir: İnsanlar (hücreler) birbirleriyle nasıl etkileşiyor? Çevreleri (plazma) ne kadar temiz? Yollar (dolaşım) açık mı? Enerjileri yerinde mi?
Bu teknikte, parmak ucunuzdan alınan tek bir damla kan, boyanmadan veya herhangi bir kimyasal işleme maruz bırakılmadan, canlı haliyle özel bir mikroskop altında incelenir. Özel bir aydınlatma tekniği sayesinde hücreler ve diğer elementler parlak bir şekilde belirginleşirken, arka plan karanlık kalır. Bu da bize kanınızın yaşayan, dinamik dünyasına anlık bir bakış atma imkanı verir.
Bir Damla Kanda Neleri Görüyoruz?
Bu canlı haritada, uzmanlarımız sağlığınızın genel durumu hakkında paha biçilmez ipuçları arar:
- Kırmızı Kan Hücrelerinin (Eritrositler) Durumu: Sağlıklı kırmızı kan hücreleri yuvarlak, ayrı ve serbestçe hareket eder. Ancak dehidrasyon, zayıf protein sindirimi veya vücut asiditesinin artması gibi durumlarda, birbirlerine yapışarak "Rouleaux" adı verilen para dizileri oluşturabilirler. Bu, oksijen taşınma kapasitesinin ve dolaşımın verimsizleştiğinin bir işaretidir.
- Beyaz Kan Hücrelerinin (Lökositler) Aktivitesi: Bağışıklık sisteminizin askerleri olan beyaz kan hücrelerinin sayısı kadar, aktivitesi de önemlidir. Onları canlı olarak izlemek, ne kadar hareketli ve "savaşmaya hazır" oldukları hakkında fikir verir. Yavaş veya hareketsiz hücreler, zayıflamış bir bağışıklık sistemine işaret edebilir.
- Plazmanın Temizliği (Biyolojik "Terrain"): Hücrelerinizin yüzdüğü bu sıvı ortam, vücudunuzun iç ekosistemidir. Plazmada sindirilmemiş yağ globülleri, ürik asit kristalleri, sindirim sorunlarına işaret eden protein kümeleri veya istenmeyen mikrobiyal formlar (maya, bakteri vb.) gibi normalde olmaması gereken unsurları gözlemleyebiliriz.
- Vitamin ve Mineral Eksikliklerinin İşaretleri: Bazı vitamin ve mineral eksiklikleri, kan hücrelerinin yapısında veya plazmada spesifik belirtilerle kendini gösterebilir.
Bu Bir Teşhis Değil, Bir Farkındalık Aracıdır
Önemle belirtmek gerekir ki, Karanlık Alan Mikroskobu kanser veya diyabet gibi spesifik hastalıkların teşhisini koymak için kullanılmaz. Amacı, vücudunuzun biyolojik "terrain"inin, yani iç dengesinin ne durumda olduğunu göstermektir. Bu, sorunlar kronikleşmeden ve hastalığa dönüşmeden önce önlem almamızı sağlayan, proaktif (önleyici) bir sağlık aracıdır.
Cellavia'da Karanlık Alan Analizi Nasıl Bir Yol Haritası Sunar?
Gördüğümüz manzara, sizin için tamamen kişiselleştirilmiş bir wellness programının başlangıç noktasıdır. Analiz sonuçlarına göre:
- Beslenme düzeninizde yapmanız gereken değişiklikleri belirleyebiliriz.
- Hangi takviyelere veya vitaminlere gerçekten ihtiyacınız olduğunu saptayabiliriz.
- Detoks veya sindirim sistemini destekleyici programlar önerebiliriz.
- IV Terapiler gibi uygulamalarla eksikliklerinizi hızla yerine koyabiliriz.
Kanınızın size anlattığı gizli hikayeyi keşfetmeye hazır mısınız? Vücudunuzun derinliklerine bir yolculuk yapmak ve sağlığınızın kontrolünü en temelden elinize almak için Cellavia'da Canlı Kan Analizi randevunuzu alın.